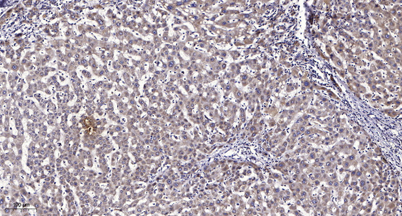

LRP11 rabbit pAb
 One-click to copy product information
One-click to copy product information$148.00/50µL $248.00/100µL
| 50 µL | $148.00 |
| 100 µL | $248.00 |
Overview
| Product name: | LRP11 rabbit pAb |
| Reactivity: | Human;Rat;Mouse; |
| Alternative Names: | LRP11; Low-density lipoprotein receptor-related protein 11; LRP-11 |
| Source: | Rabbit |
| Dilutions: | WB 1:500-2000;IHC-p 1:50-300 |
| Immunogen: | The antiserum was produced against synthesized peptide derived from human LRP11. AA range:48-97 |
| Storage: | -20°C/1 year |
| Clonality: | Polyclonal |
| Isotype: | IgG |
| Concentration: | 1 mg/ml |
| Observed Band: | 50kD |
| GeneID: | 84918 |
| Human Swiss-Prot No: | Q86VZ4 |
| Cellular localization: | Membrane ; Single-pass type I membrane protein . |
| Background: | similarity:Belongs to the LDLR family.,similarity:Contains 1 LDL-receptor class A domain.,similarity:Contains 1 MANSC domain.,similarity:Contains 1 PKD domain., |
-
 Western blot analysis of lysates from Jurkat cells, using LRP11 Antibody. The lane on the right is blocked with the synthesized peptide.
Western blot analysis of lysates from Jurkat cells, using LRP11 Antibody. The lane on the right is blocked with the synthesized peptide. -
Immunohistochemical analysis of paraffin-embedded human liver cancer. 1, Antibody was diluted at 1:200(4° overnight). 2, Tris-EDTA,pH9.0 was used for antigen retrieval. 3,Secondary antibody was diluted at 1:200(room temperature, 45min).
Immunohistochemical analysis of paraffin-embedded human liver cancer. 1, Antibody was diluted at 1:200(4° overnight). 2, Tris-EDTA,pH9.0 was used for antigen retrieval. 3,Secondary antibody was diluted at 1:200(room temperature, 45min).

 Manual
Manual